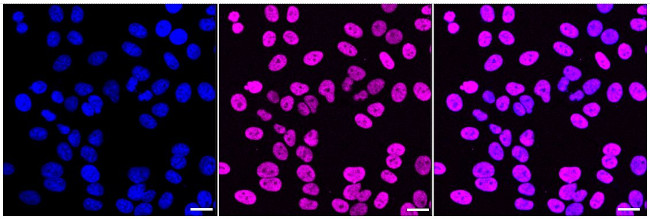
TRBP Antibody in Immunocytochemistry (ICC/IF)

Search
Invitrogen
TRBP Recombinant Rabbit Monoclonal Antibody (24GB2425)
{{$productOrderCtrl.translations['antibody.pdp.commerceCard.promotion.promotions']}}
{{$productOrderCtrl.translations['antibody.pdp.commerceCard.promotion.viewpromo']}}
{{$productOrderCtrl.translations['antibody.pdp.commerceCard.promotion.promocode']}}: {{promo.promoCode}} {{promo.promoTitle}} {{promo.promoDescription}}. {{$productOrderCtrl.translations['antibody.pdp.commerceCard.promotion.learnmore']}}
图: 1 / 4
TRBP Antibody (MA5-57764) in ICC/IF




Please note: We are reviewing Western blot images included in the antibody testing data in our catalog, including those provided by third parties. Unless expressly labeled or annotated as “raw-unedited”, Western blot images included in the antibody testing data in our catalog may have been edited, optimized or otherwise adjusted for presentation.
产品信息
MA5-57764
种属反应
宿主/亚型
Expression System
分类
类型
克隆号
抗原
偶联物
形式
纯化类型
保存液
内含物
保存条件
运输条件
RRID
靶标信息
TRBP belongs to the family of dsRNA-binding proteins. It consists of highly conserved 2 dsRNA-binding domains and C-terminal basic region. It is a unique cellular protein capable of binding to HIV-TAR RNA and stimulates expression of HIV-1 long terminal repeats. It also inhibits the host antiviral and anti-proliferative mechanisms by directly binding to IFN-regulated dsRNA-dependent protein kinase (PKR). TRBP associates with Ago2 protein and forms an integral component of Dicer-containing complex. It has a role in micro RNA processing and in RISC assembly. Other functions of TRBP include promoting cellular growth and tumorigenesis.
仅用于科研。不用于诊断过程。未经明确授权不得转售。
篇参考文献 (0)
生物信息学
蛋白别名: PRM-1 RNA-binding protein; Protamine-1 RNA-binding protein; RISC-loading complex subunit TARBP2; RISC-loading complex subunit TARBP2 {ECO:0000255|HAMAP-Rule:MF_03034}; TAR (HIV) RNA binding protein 2; TAR RNA-binding protein 2; Trans-activation-responsive RNA-binding protein
基因别名: Prbp; TARBP2; TRBP
UniProt ID: (Mouse) P97473, (Rat) Q3SWU0
Entrez Gene ID: (Mouse) 21357, (Rat) 363006